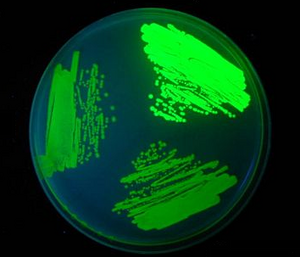

User:Daneil Peng Xu: Difference between revisions
From OpenWetWare
Jump to navigationJump to search
No edit summary |
No edit summary |
||
| Line 1: | Line 1: | ||
==Contact Info== | ==Contact Info== | ||
[[Image: | [[Image:GFP.tif|right|thumb]] | ||
* | *Peng Xu | ||
*[http://biotech.rpi.edu/ Center for Biotechnology and Interdisciplinary Studies] | |||
*Chemical and Biological Engieering, Rensselaer Polytechnic Institute | *Chemical and Biological Engieering, Rensselaer Polytechnic Institute | ||
* | *110 Eighth Street | ||
* | *Troy, NY 12180, USA. | ||
*[[Special:Emailuser/Peng Daniel Xu|pxu999 at gmail dot com]] | |||
*[[Special:Emailuser/ | |||
I work in the [[ | I work in the [[Koffas Lab]] at [http://www.rpi.edu/ Rensselaer Polytechnic Institute]. Before we moved to RPI at February 2011, I have studied at the [http://www.buffalo.edu/ State University of New York at Buffalo]] for two and a half years. My research interests include creating novel microbial platforms for producing flavonoids and fatty acids through a combination of metabolic engineering and synthetic biology approach. | ||
==Education== | ==Education== | ||
<!--Include info about your educational background--> | <!--Include info about your educational background--> | ||
* | * December 2012 (expected),PhD in Metabolic Engineering,[http://www.rpi.edu/ Rensselaer Polytechnic Institute] | ||
* | * 2006, MS in Biochemical Engineering, [http://www.jiangnan.edu.cn/ Jiangnan University] (Formerly Southern Yangtze University) | ||
* | * 2003, BS in Biotechnology, [http://www.jiangnan.edu.cn/ Jiangnan University] (Formerly Southern Yangtze University) | ||
==Research interests== | ==Research interests== | ||
<!-- Feel free to add brief descriptions to your research interests as well --> | <!-- Feel free to add brief descriptions to your research interests as well --> | ||
# | # Metabolic engineering | ||
# | # Synthetic biology | ||
# | # Natural Products/Biofuels | ||
# Biochemical/Bioprocess engineering | |||
==Publications== | ==Publications== | ||
<!-- Replace the PubMed ID's ("pmid=#######") below with the PubMed ID's for your publications. You can add or remove lines as needed --> | <!-- Replace the PubMed ID's ("pmid=#######") below with the PubMed ID's for your publications. You can add or remove lines as needed --> | ||
[http://www.researcherid.com/rid/C-6440-2011 My research ID profile] | |||
# | # Xu, P; Ding, ZY; Qian, Z; et al. [http://www.sciencedirect.com/science/article/pii/S0141022907003407 Improved production of mycelial biomass and ganoderic acid by submerged culture of Ganoderma lucidum SB97 using complex media], Enzyme and Microbial Technology Volume: 42 Issue: 4 Pages: 325-331 | ||
# | # Zhang, TX; Xu, P; Sun, J; et al. [http://apps.isiknowledge.com/InboundService.do?product=WOS&action=retrieve&SrcApp=RID&UT=000263481500005&SID=3CjOGJ5LO3kk6iLg4d1&Init=Yes&SrcAuth=RID&mode=FullRecord&customersID=RID&DestFail=http%3A%2F%2Faccess.isiproducts.com%2Fcustom_images%2Fwok_failed_auth.html Identification of Biological Wort Turbidity Caused by Microbial Contamination of Gairdner Barley], Journal of the American Society of Brewing Chemists Volume: 67 Issue: 1 Pages: 33-37 | ||
// | # Xu, Peng; Koffas, Mattheos A. G. [http://www.future-science.com/doi/abs/10.4155/bfs.10.13 Metabolic engineering of Escherichia coli for biofuel production], Biofuels Volume: 1 Issue: 3 Pages: 493-504 | ||
==Useful links== | ==Useful links== | ||
*[[OpenWetWare:Welcome|Introductory tutorial]] | *[[OpenWetWare:Welcome|Introductory tutorial]] | ||
*[[Help|OpenWetWare help pages]] | *[[Help|OpenWetWare help pages]] | ||
Revision as of 19:06, 9 June 2011
Contact Info
- Peng Xu
- Center for Biotechnology and Interdisciplinary Studies
- Chemical and Biological Engieering, Rensselaer Polytechnic Institute
- 110 Eighth Street
- Troy, NY 12180, USA.
- pxu999 at gmail dot com
I work in the Koffas Lab at Rensselaer Polytechnic Institute. Before we moved to RPI at February 2011, I have studied at the State University of New York at Buffalo] for two and a half years. My research interests include creating novel microbial platforms for producing flavonoids and fatty acids through a combination of metabolic engineering and synthetic biology approach.
Education
- December 2012 (expected),PhD in Metabolic Engineering,Rensselaer Polytechnic Institute
- 2006, MS in Biochemical Engineering, Jiangnan University (Formerly Southern Yangtze University)
- 2003, BS in Biotechnology, Jiangnan University (Formerly Southern Yangtze University)
Research interests
- Metabolic engineering
- Synthetic biology
- Natural Products/Biofuels
- Biochemical/Bioprocess engineering
Publications
- Xu, P; Ding, ZY; Qian, Z; et al. Improved production of mycelial biomass and ganoderic acid by submerged culture of Ganoderma lucidum SB97 using complex media, Enzyme and Microbial Technology Volume: 42 Issue: 4 Pages: 325-331
- Zhang, TX; Xu, P; Sun, J; et al. Identification of Biological Wort Turbidity Caused by Microbial Contamination of Gairdner Barley, Journal of the American Society of Brewing Chemists Volume: 67 Issue: 1 Pages: 33-37
- Xu, Peng; Koffas, Mattheos A. G. Metabolic engineering of Escherichia coli for biofuel production, Biofuels Volume: 1 Issue: 3 Pages: 493-504